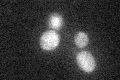
YLR427W
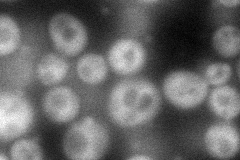
YLR427W
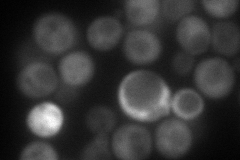
YLR427W
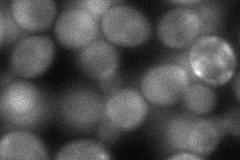
YLR427W
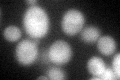
YLR427W
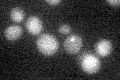
YLR427W

View description
Cytoplasmic protein of unknown function; induced in response to mycotoxin patulin; ubiquitinated protein similar to the human ring finger motif protein RNF10; predicted to be involved in repair of alkylated DNA due to interaction with MAG1
Localization:
Intensity:
Fold change:
Significance:
-
C’ GFP library in SD
cytosol24.22 -
N' NOP1pr-GFP in SD
cytosol85.6954 -
N' TEF2pr-mCherry in SD
cytosol85.3659 -
N' NATIVEpr-GFP in SD

cytosol26.8542 -
N' TEF2pr-VC and Cyto-VN in SD
cytosol56.4612 -
C’ GFP library in SD+DTT
cytosol31.181.28No -
C’ GFP library in SD+H2O2

cytosol29.631.22No -
C’ GFP library in Starvation Media
cytosol20.360.84No -
C’ GFP library on the background of Pup2-DaMP

cytosol -
C’ GFP library on the background of CCT mutant

cytosol26.19511.0812No
